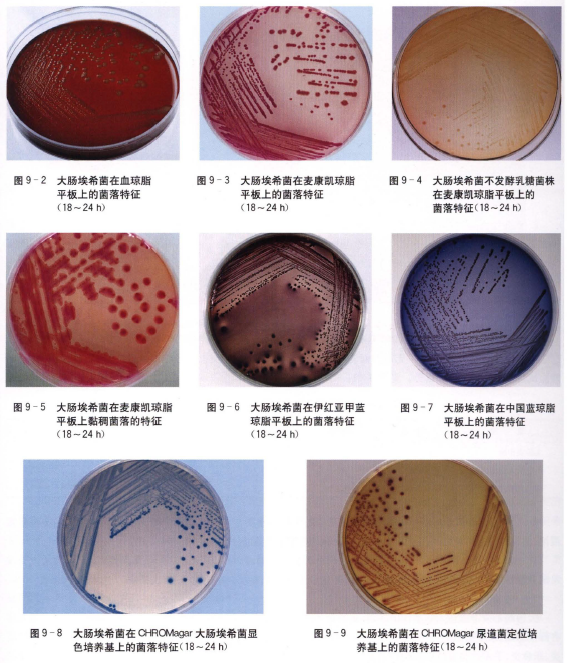

海博微信公众号
海博微信公众号
 海博天猫旗舰店
海博天猫旗舰店


 海博微信公众号
海博微信公众号
 海博天猫旗舰店
海博天猫旗舰店




革兰阴性杆菌,粗短,大小为(1. 1 ~ 1. 5)μm X(2. 0 ~ 6.0)μm( 图9-1),多数有周鞭毛。

(二) 培养特性
在血琼脂平板上35℃ 培养18~24h ,呈圆形、直径为2~3mm 、稍凸、边缘整齐、灰白色、不透明的菌落(图9 - 2) ,少数菌株产生R 溶血环。在麦康凯琼脂平板上形成不透明、粉红色菌落(图9 - 3) ,部分不发酵乳糖的菌株呈无色菌落(图9 - 4) ,少数呈黠稠状菌落(图9 一5) 。在伊红亚甲蓝琼脂平板上菌落呈紫黑色,并有金属光泽(图9 - 6) 。在中国蓝琼脂平板上菌落呈蓝色(图9 一7) 。在XLD 琼脂平板上菌落呈不透明黄色。在H -E 琼脂平板上菌落呈黄色。在CHROMagar 大肠埃希菌显色培养基上呈蓝色菌落(图9 - 8) 。在CH ROMagar 尿道菌定位培养基上菌落呈红色(图9 - 9) 。
( 三)生化反应
1.氧化酶试验阴性、三糖铁(TSD 琼脂为A/ A( 图9 一10) ,发酵葡萄糖、乳糖、甘露醇等多种糖类,产酸产气,不发酵卫矛醇、肌醇,动力、赖氨酸脱竣酶和硝酸盐还原试验阳性,腮酶、丙二酸盐、苯丙氨酸脱氨酶试验均为阴性, IMViC++ 一一(占94.6 %)( 图9 - 11) 。

2 . 致病性大肠埃希菌包括肠产毒型大肠埃希菌(enterotoxigenic E. coli , ETEC) 、肠致病型大肠埃希菌(enteropathogenic E. coli , EPEC)、肠侵袭型大肠埃希菌(enteroinvasive E. coli , EIEC) 、肠出血型大肠埃希菌(enterohemorrhagic E. coli , EHEC) 和肠凝聚型大肠埃希菌(enteroaggregative E. coli , EAggEC) 5 群。经生化反应鉴定为大肠埃希菌后进行血清学试验(0 、H 和K 抗原)、毒性试验(ST 和LT 肠毒素)和临床症状,分别鉴定5 型致病性大肠埃希菌。
(四) 鉴别要点
1.本菌特征TSI 为A/ A ,发酵葡萄糖、乳糖、甘露醇等多种糖类,产酸产气, IMViC++--。
2 . 与痢疾志贺菌的鉴别无动力而乳糖迟发酵的菌株,易与嗣疾志贺菌相混淆,可通过赖氨酸脱竣酶、醋酸盐试验等和血清分型法区分。见表9 -1 。
3 . 与肺炎克雷伯菌的鉴别少数蒙古液样菌落的大肠埃希菌在麦康凯琼脂平板上易与肺炎克雷伯菌菌落相混淆,大肠埃希菌教液样菌落呈深粉红色,而肺炎克雷伯菌则呈浅粉红色。
4 . 产腺酶的大肠埃希菌变种与普通变形杆菌的鉴别两者IMViC 试验均为++--,但产腮酶的大肠埃希菌发酵甘露醇,苯丙氨酸脱氨酶试验阴性;普通变形杆菌则相反。
(五) 临床意义
大肠埃希菌寄居在人和动物的肠道,是肠道正常菌群,也是医院感染和社区感染的常见病原菌,可引起人体各部位感染,以尿路感染为主(尿路感染中大肠埃希菌其比例可达90 % ) 。还可引起菌血症、败血症、新生儿脑膜炎、胆囊炎、手术后腹腔感染及灼伤创面感染等疾病。产生超广谱R 一内l酷胶酶(ESBLs) 是大肠埃希菌最主要的耐药机制之一。ESBLs 大部分由质粒介导,常见为TEM 型及SHV 型广谱酶衍生的超广谱ß - 内酷肢酶,还包括PER 型酶及CTX 型酶等,中国ESBLs 基因型的CTX-M 型为主。如果检出产ESBLs 大肠埃希菌,即使体外药敏试验对青霉素类、头子包菌素类或氨由南敏感,也应报告该菌对所有青霉素类、头子包菌素类或氨曲南耐药。临床上危重感染首选碳青霉烯类抗生素进行治疗。
上一篇:肥达氏反应



